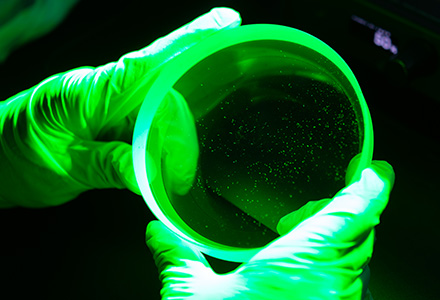
X-Loupe Inspection Task Lighting

Photo

Searching for Wafer alien particles / scratch inspection Comparison : (Left) Under ambient light ; (Right) Under collimated green light

Searching for alien particles / scratch inspection on mask with pellicle. Comparison : (Upper) Under 4000K White Light can find dust; (Bottom) Under collimated green light can see other particles.

Dual color light switching base on various work demands. Warm white light will not affect exposure work.Under collimated green light, Human eyes have high contrast sensitiveness to see fine dust and particles.
Inspectors could find sticky dust particles on Optical Lens efficiently. Comparison: (Upper left) lens under ambient light ; (Upper right) lens under collimated green light looks unqualified.

Inspectors could find sticky dust particles on Optical Lens efficiently. Comparison: (Upper left) lens under ambient light ; (Upper right) lens under 4000K white light unqualified.

Inspectors could find sticky dust particles on LCD efficiently. Comparison: (Upper left) lens under ambient light ; (Upper right) lens under collimated green light unqualified.

Inspectors could find sticky dust particles on LCD efficiently. Comparison: (Upper left) lens under ambient light ; (Upper right) lens under collimated 4000K white light seem unqualified.




























